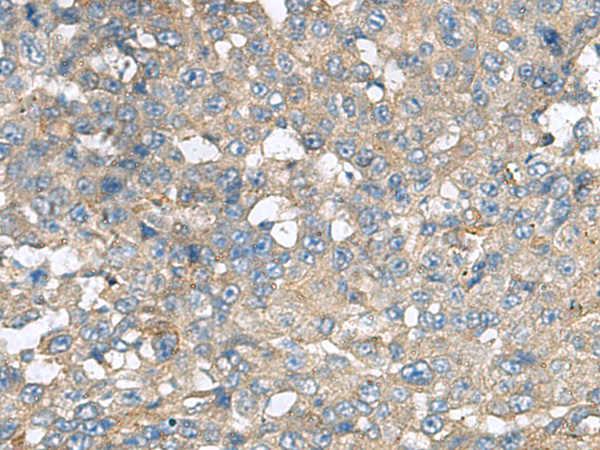

|
Background: |
This gene encodes a multi-pass membrane protein that belongs to the CXC chemokine receptor family. It is expressed in mature B-cells and Burkitt's lymphoma. This cytokine receptor binds to B-lymphocyte chemoattractant (BLC), and is involved in B-cell migration into B-cell follicles of spleen and Peyer patches. Alternatively spliced transcript variants encoding different isoforms have been described for this gene. |
|
Applications: |
ELISA, IHC |
|
Name of antibody: |
CXCR5 |
|
Immunogen: |
Synthetic peptide of human CXCR5 |
|
Full name: |
C-X-C motif chemokine receptor 5 |
|
Synonyms: |
BLR1; CD185; MDR15 |
|
SwissProt: |
P32302 |
|
ELISA Recommended dilution: |
5000-10000 |
|
IHC positive control: |
Human liver cancer and Human colorectal cancer |
|
IHC Recommend dilution: |
50-200 |

購(gòu)物車(chē)
購(gòu)物車(chē) 幫助
幫助
 021-54845833/15800441009
021-54845833/15800441009
